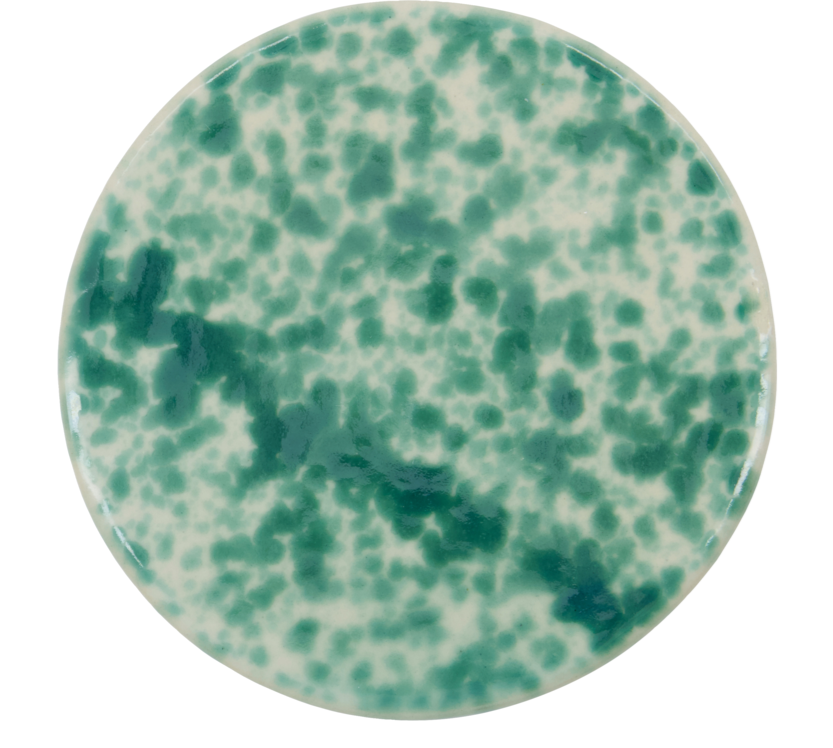

Runde Servierplatte Diva
Lieferzeit: 3 - 5 Werktage
Kostenloser Versand ab 99,- € Bestellwert
Zahlung auf Rechnung & andere sichere Bezahlwege
Plastikfreier und Co2-neutraler Versand
Inhabergeführter Shop und frauengeführtes Unternehmen seit 2012
Bringe frische Farbe auf deinen Tisch mit diesem handbemalten, runden Keramik-Servierbrett! Das moderne grüne Splash-Muster sorgt für einen besonderen Akzent und macht das Servieren von Tapas, Käse oder Desserts zu einem echten Hingucker. Ideal als Sharing Board – perfekt für gemütliche Abende mit Freunden oder Familie. Genieße die Kombination aus Stil und Funktionalität, die dieses Set bietet.
-
Handbemaltes grünes Splash-Muster für einen einzigartigen Look
-
Perfekt für Tapas, Käse und Desserts
-
Modernes Design, das deinem Tisch das gewisse Etwas verleiht
-
Praktisch und vielseitig einsetzbar
Bringe noch heute einen Hauch von Farbe und Stil auf deinen Tisch – mit diesen Servierbrettern wird jedes Essen zu einem Highlight!
Größe: h: 1 cm, d: 15 cm
Materialen: Steinzeug
Lebensmittelecht
Kann variieren: Finish, Farbe, Größe
Zugelassen für Mikrowelle
Nicht für den Backofen zugelassen, Max temperature Arra
Spülmaschinenfest, max Temperatur 40 Grad
VERSAND & RETOUREN
Unsere Versandkosten betragen:
Deutschland: 6,90 Euro, versandkostenfrei ab einem Bestellwert von 99,- Euro
(ausgenommen bestimmte Produkte, die per Spedition geliefert werden)
EU: 14,90 Euro, versandkostenfrei ab einem Bestellwert von 99,- Euro
Schweiz: 24,90 Euro
International: 24,90 Euro
Auf jeder Produktseite sind die Lieferzeiten für den entsprechenden Artikel angegeben.
Solltest du dein Paket nicht erhalten haben, kontaktiere bitte unseren Kundenservice über das Kontaktformular.
Wenn du von deinem Widerrufsrecht Gebrauch machst, kannst du die Ware ohne Angaben von Gründen innerhalb von 14 Tagen auf deine Kosten an uns zurücksenden.
Bei unversicherten Retouren können wir keine Erstattung z.B bei Transportschäden oder Verlust vornehmen. „Unfreie“ Rücksendungen können wir nicht annehmen.
Die Abwicklung deiner Retoure kann bis zu 14 Tage in Anspruch nehmen.
Optionen auswählen